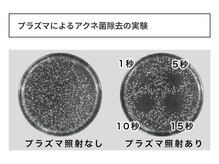
キュレイテッドスキン(CURATED SKIN)/

美肌育成salon CURATED SKIN【キュレイテッドスキン】
ビハダイクセイサロン キュレイテッドスキン
- エステ
- リラク
- 兵庫県神戸市中央区琴ノ緒町3丁目2-22 シェワズレガリア302
- JR三ノ宮駅・阪急神戸線神戸三宮駅・阪神本線神戸三宮駅の各駅から徒歩5分
キュレイテッドスキン(CURATED SKIN)のクーポン
- 新規
- サロンに初来店の方
- 再来
- サロンに2回目以降にご来店の方
- 全員
- サロンにご来店の全員の方
|
新 規 |
¥1,500引き 【2/23~27限定 | ご縁枠】肌管理フルコース 全メニューでご利用可能!
|
|
再 来 |
¥500引き 来店後のレビューで500円引き
|
|
全 員 |
¥56,500 ラミネーションピーリング回数券【期間限定SALE】2月28日まで
|
|
新 規 |
¥18,850 【ラミネーションピーリング】×プラズマ 120min.艶と透明感の集中美肌コース
|
|
新 規 |
¥11,000 【レモンボトル】人気の脂肪分解!気になる箇所集中ケア
|
|
全 員 |
¥56,100 ニキビケア/凹凸改善/シミケア回数券【期間限定SALE】2月28日まで
|